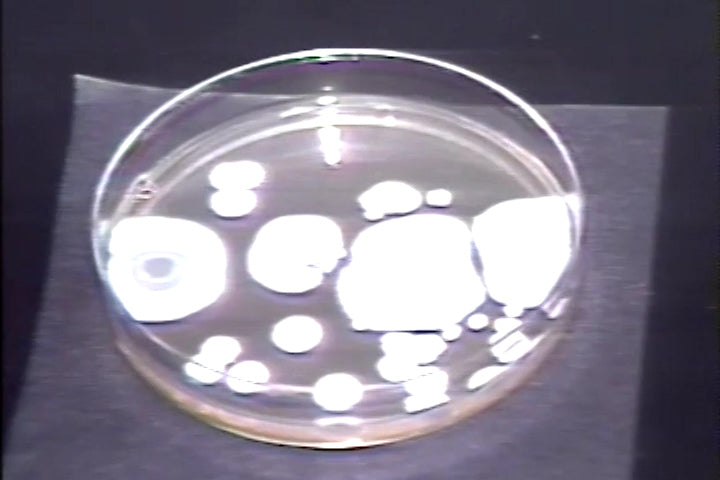

Hotel Safety Series - Sanitation and Health For Food Service Workers
$300.00
SKU 5004A
Foodborne illness is quite prevalent in the home, restaurants, hotels, and retail establishments. Through someone's carelessness, micro-organisms were allowed to get on food. The program will focus on cleanliness, sanitation, food temperatures, and good housekeeping. Key Words: Sanitation, Cafeteria, Food Service, Food Temperatures, Good Housekeeping, Foodborne Illness, Restaurants, Hotels, Retail, School Cafeterias, Carelessness, Micro Organism, Food, Chicken, Beef, Safety Video, Safety Training, Safety .